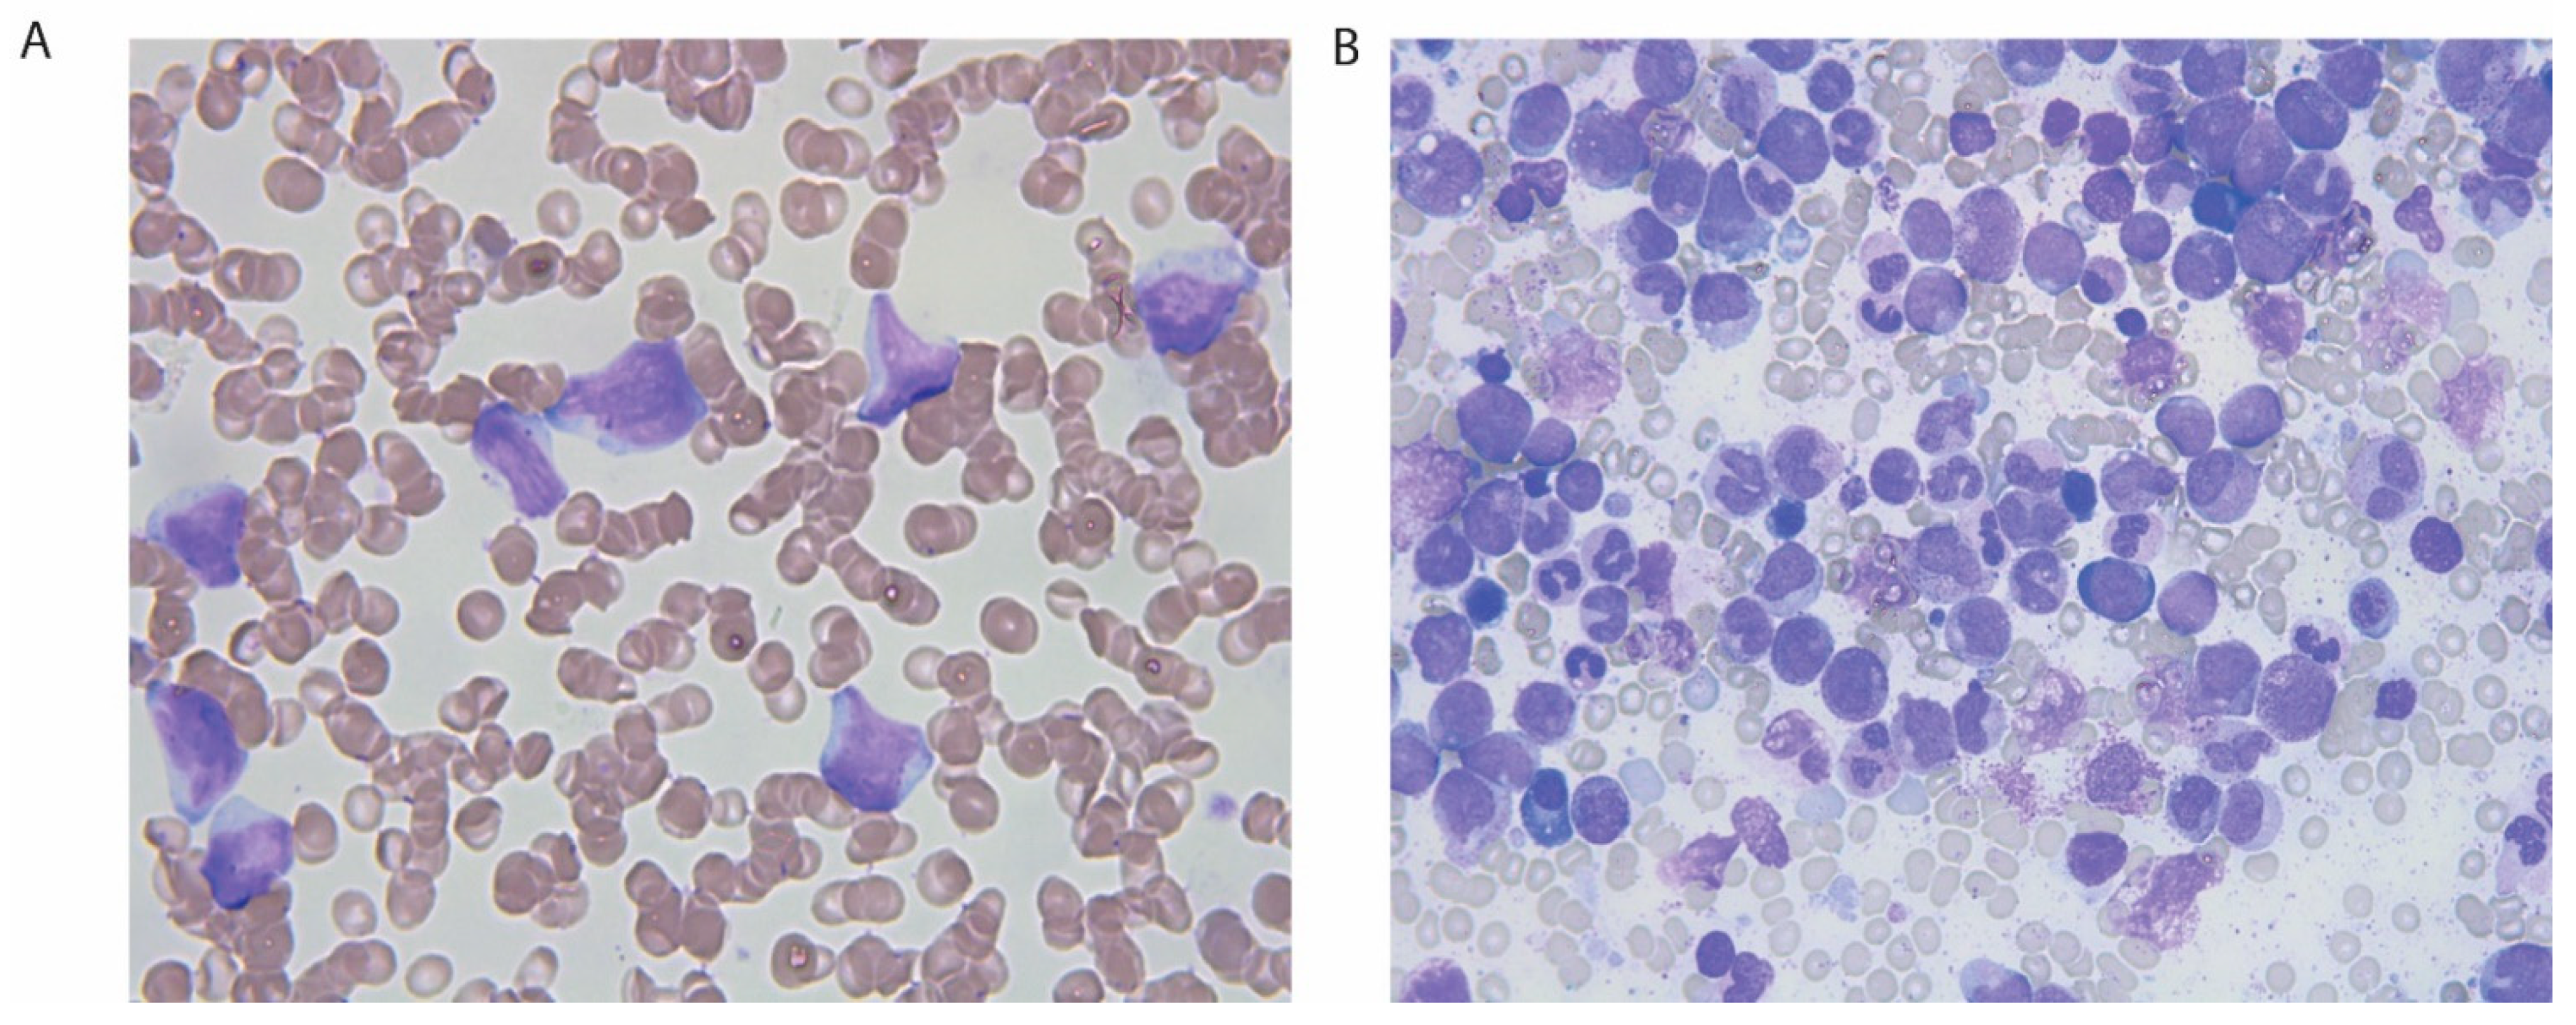
Clinpract 11 00061 g002 Clinpract 11 00061 g002

Kidney Failure and Abdominal Discomfort as Initial Signs of Extramedullary Acute Myelogenous Leukemia
Abstract
1. Introduction
2. Case Presentation
3. Discussion
Author Contributions
Funding
Institutional Review Board Statement
Informed Consent Statement
Conflicts of Interest
References
- Humphreys, B.D.; Soiffer, R.J.; Magee, C.C. Renal failure associated with cancer and its treatment: An update. J. Am. Soc. Nephrol. 2005, 16, 151–161. [Google Scholar] [CrossRef] [PubMed]
- Cohen, L.J.; Rennke, H.G.; Laubach, J.P.; Humphreys, B.D. The spectrum of kidney involvement in lymphoma: A case report and review of the literature. Am. J. Kidney Dis. 2010, 56, 1191–1196. [Google Scholar] [CrossRef] [PubMed]
- Rosner, M.H.; Perazella, M.A. Acute Kidney Injury in Patients with Cancer. N. Engl. J. Med. 2017, 376, 1770–1781. [Google Scholar] [CrossRef]
- Bakst, R.L.; Tallman, M.S.; Douer, D.; Yahalom, J. How I treat extramedullary acute myeloid leukemia. Blood 2011, 118, 3785–3793. [Google Scholar] [CrossRef] [PubMed]
- Dohner, H.; Estey, E.; Grimwade, D.; Amadori, S.; Appelbaum, F.R.; Buchner, T.; Dombret, H.; Ebert, B.L.; Fenaux, P.; Larson, R.A.; et al. Diagnosis and management of AML in adults: 2017 ELN recommendations from an international expert panel. Blood 2017, 129, 424–447. [Google Scholar] [CrossRef] [PubMed]
- Mayer, R.J.; Davis, R.B.; Schiffer, C.A.; Berg, D.T.; Powell, B.L.; Schulman, P.; Omura, G.A.; Moore, J.O.; McIntyre, O.R.; Frei, E., 3rd. Intensive postremission chemotherapy in adults with acute myeloid leukemia. Cancer and Leukemia Group B. N. Engl. J. Med. 1994, 331, 896–903. [Google Scholar] [CrossRef] [PubMed]
- Rishor-Olney, C.R.; Hinson, M.R. Obstructive Uropathy. In StatPearls; StatPearls Publishing: Treasure Island, FL, USA, 2020. [Google Scholar]
- Dohner, H.; Weisdorf, D.J.; Bloomfield, C.D. Acute Myeloid Leukemia. N. Engl. J. Med. 2015, 373, 1136–1152. [Google Scholar] [CrossRef] [PubMed]
- Shallis, R.M.; Gale, R.P.; Lazarus, H.M.; Roberts, K.B.; Xu, M.L.; Seropian, S.E.; Gore, S.D.; Podoltsev, N.A. Myeloid sarcoma, chloroma, or extramedullary acute myeloid leukemia tumor: A tale of misnomers, controversy and the unresolved. Blood Rev. 2021, 47, 100773. [Google Scholar] [CrossRef] [PubMed]
- Ravulapati, S.; Siegel, C.; Dara, A.; Lionberger, J.M. Myeloid sarcoma without circulating leukemia mimicking gastrointestinal malignancy and lymphoma. Hematol. Rep. 2018, 10, 7040. [Google Scholar] [CrossRef] [PubMed]
- Warme, B.; Sullivan, J.; Tigrani, D.Y.; Fred, D.M. Chloroma of the forearm: A case report of leukemia recurrence presenting with compression neuropathy and tenosynovitis. Iowa Orthop. J. 2009, 29, 114–116. [Google Scholar] [PubMed]
- Mawad, R.; Wu, D.; Abkowitz, J.L.; Walter, R.B. Myeloid sarcoma of the heart. Leuk. Lymphoma 2012, 53, 2511–2514. [Google Scholar] [CrossRef] [PubMed][Green Version]
- Solh, M.; Solomon, S.; Morris, L.; Holland, K.; Bashey, A. Extramedullary acute myelogenous leukemia. Blood Rev. 2016, 30, 333–339. [Google Scholar] [CrossRef] [PubMed]
- Reikvam, H.; Hatfield, K.J.; Kittang, A.O.; Hovland, R.; Bruserud, O. Acute myeloid leukemia with the t(8;21) translocation: Clinical consequences and biological implications. J. Biomed. Biotechnol. 2011, 2011, 104631. [Google Scholar] [CrossRef] [PubMed]
- Johansen, S.; Kollsete Gjelberg, H.; Ahmed, A.B.; Bruserud, O.; Reikvam, H. Myeloid Sarcoma after Allogenic Stem Cell Transplantation for Acute Myeloid Leukemia: Successful Consolidation Treatment Approaches in Two Patients. Case Rep. Oncol. Med. 2018, 2018, 7697283. [Google Scholar] [CrossRef] [PubMed]
- Solh, M.; DeFor, T.E.; Weisdorf, D.J.; Kaufman, D.S. Extramedullary relapse of acute myelogenous leukemia after allogeneic hematopoietic stem cell transplantation: Better prognosis than systemic relapse. Biol. Blood Marrow Transpl. 2012, 18, 106–112. [Google Scholar] [CrossRef] [PubMed]
- Tsimberidou, A.M.; Kantarjian, H.M.; Wen, S.; Keating, M.J.; O’Brien, S.; Brandt, M.; Pierce, S.; Freireich, E.J.; Medeiros, L.J.; Estey, E. Myeloid sarcoma is associated with superior event-free survival and overall survival compared with acute myeloid leukemia. Cancer 2008, 113, 1370–1378. [Google Scholar] [CrossRef] [PubMed]
- Movassaghian, M.; Brunner, A.M.; Blonquist, T.M.; Sadrzadeh, H.; Bhatia, A.; Perry, A.M.; Attar, E.C.; Amrein, P.C.; Ballen, K.K.; Neuberg, D.S.; et al. Presentation and outcomes among patients with isolated myeloid sarcoma: A Surveillance, Epidemiology, and End Results database analysis. Leuk. Lymphoma 2015, 56, 1698–1703. [Google Scholar] [CrossRef] [PubMed]
- Ganzel, C.; Manola, J.; Douer, D.; Rowe, J.M.; Fernandez, H.F.; Paietta, E.M.; Litzow, M.R.; Lee, J.W.; Luger, S.M.; Lazarus, H.M.; et al. Extramedullary Disease in Adult Acute Myeloid Leukemia Is Common but Lacks Independent Significance: Analysis of Patients in ECOG-ACRIN Cancer Research Group Trials, 1980–2008. J. Clin. Oncol. 2016, 34, 3544–3553. [Google Scholar] [CrossRef] [PubMed]
- Zhao, Z.; Hu, Y.; Li, J.; Zhou, Y.; Zhang, B.; Deng, S. Applications of PET in Diagnosis and Prognosis of Leukemia. Technol. Cancer Res. Treat. 2020, 19. [Google Scholar] [CrossRef] [PubMed]

Publisher’s Note: MDPI stays neutral with regard to jurisdictional claims in published maps and institutional affiliations. |
© 2021 by the authors. Licensee MDPI, Basel, Switzerland. This article is an open access article distributed under the terms and conditions of the Creative Commons Attribution (CC BY) license (https://creativecommons.org/licenses/by/4.0/).
Share and Cite
Steinfeld, P.F.; Knoop, T.; Trovik, L.H.; Gjelberg, H.K.; Haslerud, T.M.; Reikvam, H. Kidney Failure and Abdominal Discomfort as Initial Signs of Extramedullary Acute Myelogenous Leukemia. Clin. Pract. 2021, 11, 459-466. https://doi.org/10.3390/clinpract11030061
Steinfeld PF, Knoop T, Trovik LH, Gjelberg HK, Haslerud TM, Reikvam H. Kidney Failure and Abdominal Discomfort as Initial Signs of Extramedullary Acute Myelogenous Leukemia. Clinics and Practice. 2021; 11(3):459-466. https://doi.org/10.3390/clinpract11030061
Chicago/Turabian StyleSteinfeld, Peter Ferkis, Thomas Knoop, Linn Hereide Trovik, Hilde Kollsete Gjelberg, Torjan Magne Haslerud, and Håkon Reikvam. 2021. "Kidney Failure and Abdominal Discomfort as Initial Signs of Extramedullary Acute Myelogenous Leukemia" Clinics and Practice 11, no. 3: 459-466. https://doi.org/10.3390/clinpract11030061
APA StyleSteinfeld, P. F., Knoop, T., Trovik, L. H., Gjelberg, H. K., Haslerud, T. M., & Reikvam, H. (2021). Kidney Failure and Abdominal Discomfort as Initial Signs of Extramedullary Acute Myelogenous Leukemia. Clinics and Practice, 11(3), 459-466. https://doi.org/10.3390/clinpract11030061

